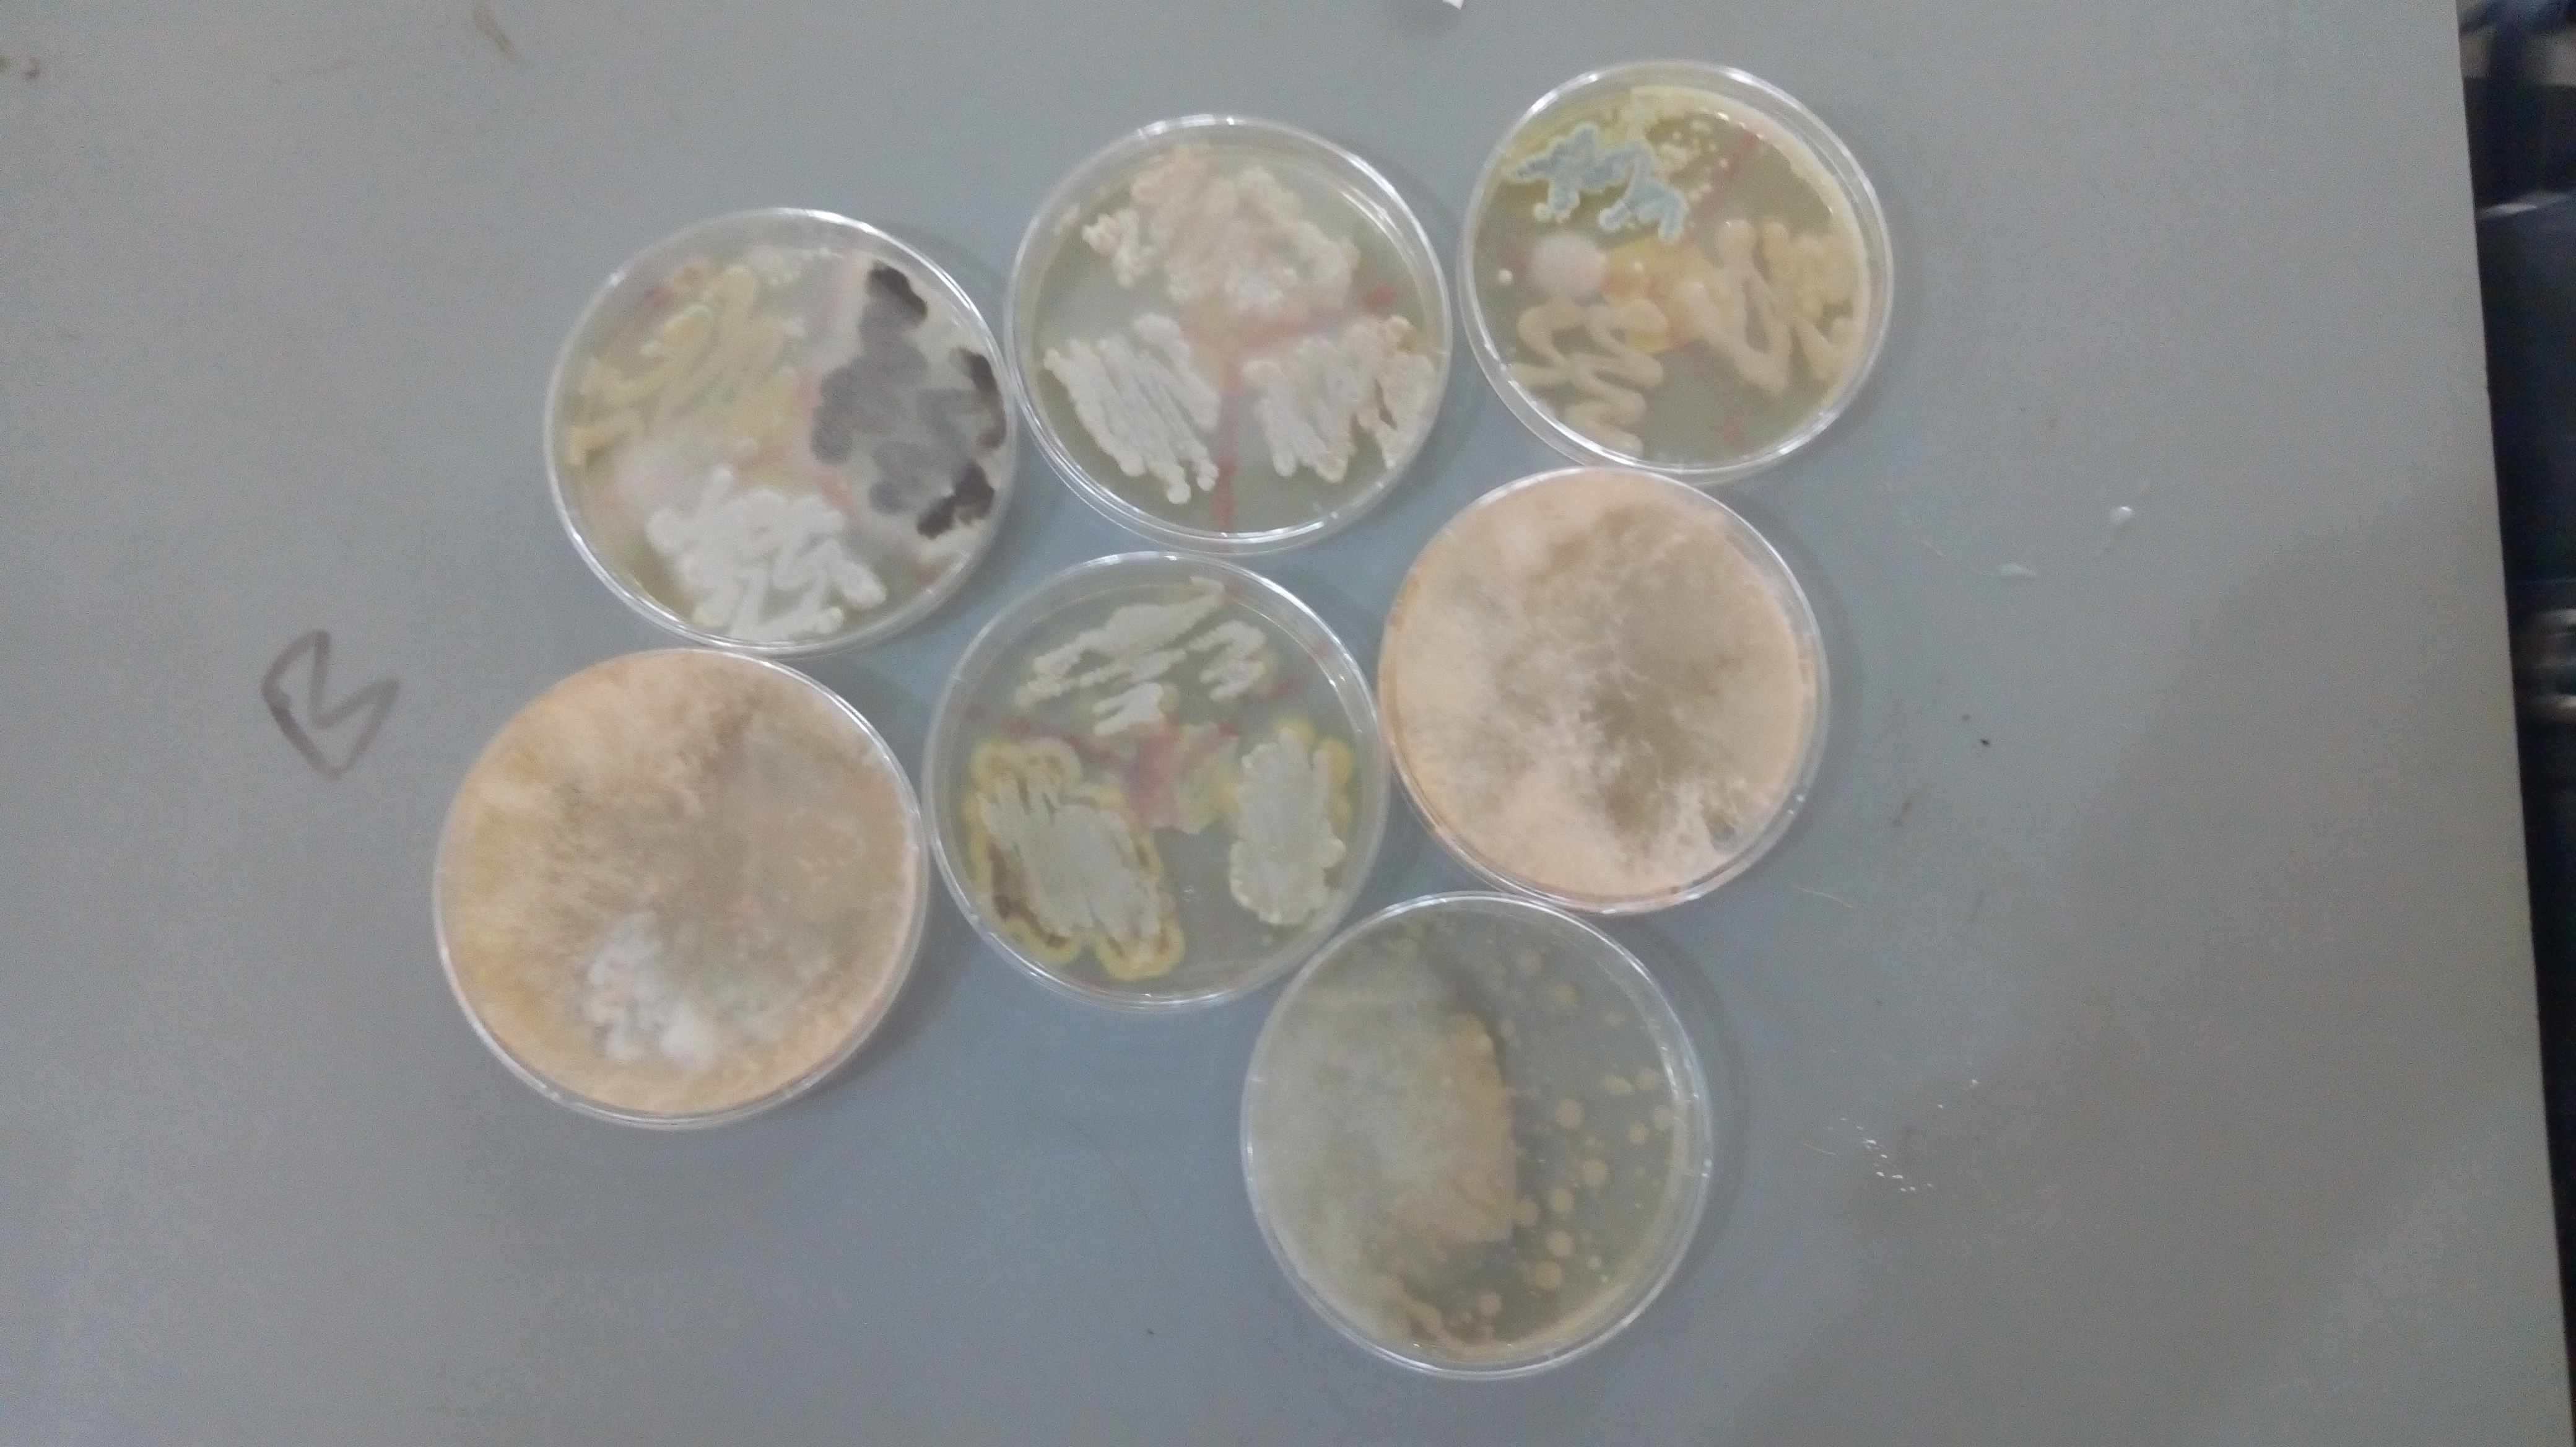
featured

tudors (62)
Junk and stuff ... ... ... ... From the third eye
558 followers4217 posts49 following211 HP
Blacklisted UsersMuted UsersFollowed BlacklistsFollowed Muted Lists
Blacklisted UsersMuted UsersFollowed BlacklistsFollowed Muted Lists
Joined December 2017 Active 5 years ago

.jpeg)
.jpeg)


